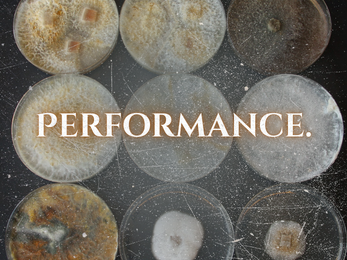

Free local delivery $100+ • Ann Arbor, Detroit, Ferndale, Hazel Park & Jackson • Call (313) 380-0171
Free delivery on orders over $100
Ann Arbor • Detroit • Ferndale • Hazel Park • Jackson
Shop STRAIN OF THE MONTH
Phone Orders Call (313) 380-0171
Open 7 days/week